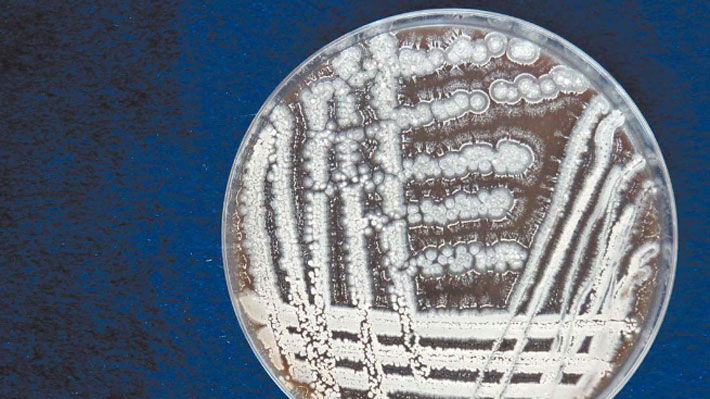

Los científicos investigan las capacidades de la streptomyces asenjonii para el desarrollo de nuevos fármacos.
El Diario de Atacama
Una colaboración entre científicos chilenos e ingleses permitió el hallazgo de una nueva bacteria en el Desierto de Atacama, uno de los ecosistemas más extremos del planeta.
Se trata de un microorganismo denominado streptomyces asenjonii, que fue encontrado en un ambiente hiper árido, a 2 mil metros de altura, y cuya exposición a condiciones inhóspitas durante miles de años le permitió desarrollar características antioxidantes y antibacterianas.
La bacteria ha sido aislada para investigar sus capacidades para el desarrollo de nuevos fármacos. Esto como parte del programa de exploración de la biósfera extrema de Atacama que realiza un equipo liderado por el Premio Nacional de Ciencias, Dr. Juan Asenjo, en busca de nuevos productos de origen natural bioactivos, informa "El Diario de Atacama".
"Hemos centrado nuestra atención en una cepa del streptomyces asenjonii, que mostró fuertes efectos antibacterianos. Estas nuevas actinobacterias filamentosas presentes en el Desierto de Atacama representa un inmenso recurso sin explotar para la búsqueda y el descubrimiento de la nueva generación de antibióticos necesarios para la atención médica", comentó el Dr. Asenso, quien además es director del Centro Basal de Biotecnología y Bioingeniería de la Universidad de Chile e integrante de la Academia Chilena de Ciencia.
El científico explicó que "esta bacteria ha sido expuesta a tremendas cantidades de radiación, resistiendo altas y bajas temperaturas, altas concentraciones de sal, presencia de óxidos inorgánicos o bajas concentraciones de materia orgánica. Muchas veces, cuando uno las encuentra, ni siquiera están vivas, sino en un estado de latencia. Pudo haber estado así por miles de años en este ambiente extremo".
Tras un análisis taxonómico, los investigadores determinaron que la bacteria sintetiza 16 metabolitos especializados, que demuestran que su adaptación a condiciones extremas le confieren una diversidad antibacteriana única. "Debido a sus condiciones únicas y aún sin explorar, la ciencia busca en estos nuevos entornos nuevas moléculas anticancerígenas y antobióticos. En el caso de esta molécula, el asenjoniii, en particular, tiene una capacidad antioxidante muy importante, algo que podría tener un enorme potencial para enfermedades asociadas al envejecimiento, según hemos observado en pruebas para determinar su composición química", señaló.
El streptomyces asenjonii es uno de los más de dos mil microorganismos que han sido encontrados en los últimos 30 años en el Desierto de Atacama. El Dr. Asenjo destacó que el hallazgo es fruto de una extensa colaboración con investigadores ingreses, entre ellos el científico Allan Bull, de la Universidad de Kent, quienes han explorado el Desierto de Atacama desde 2004.